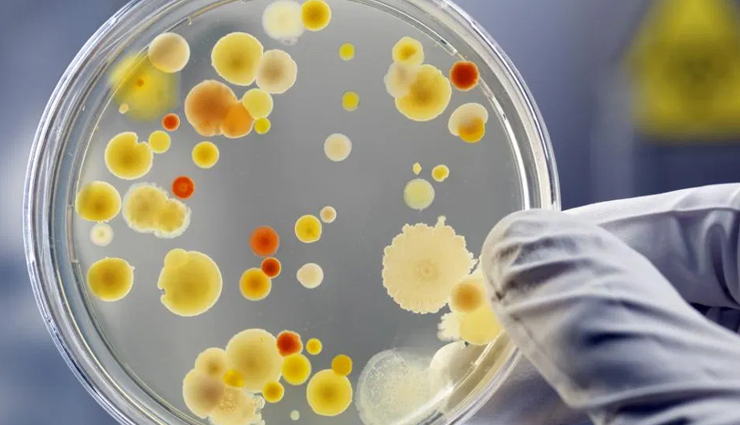
clove health benefits,uses of cloves for health,clove benefits for the body,advantages of consuming cloves,cloves for wellness,clove properties for health,benefits of adding cloves to your diet,clove spice advantages,clove-infused health benefits,cloves for better health,लौंग के स्वास्थ्य लाभ,स्वास्थ्य के लिए लौंग के फायदे,लौंग के लाभ शरीर के लिए,लौंग के सेवन के फायदे,लौंग स्वास्थ्य के लिए,लौंग की गुणवत्ता स्वास्थ्य के लिए,अपने आहार में लौंग जोड़ने के लाभ,लौंग मसाले के फायदे,लौंग से जुड़े स्वास्थ्य लाभ,स्वास्थ्य के लिए लौंग

लौंग एक लोकप्रिय मसाला है जिसका इस्तेमाल भारतीय भोजन में बहुत किया जाता है। औषधीय गुणों से भरपूर लौंग का सेवन करने से सेहत को कई प्रकार के लाभ मिलते है। प्राचीन समय से ही भोजन के स्वाद को बढ़ाने से लेकर कई तरह की दवाइयों के निर्माण तक में लौंग का इस्तेमाल लिया जाता रहा है। लौंग में विटामिन सी, फाइबर, प्रोटीन, मिनरल्स के साथ एंटीऑक्सिडेंट भी भरपूर मात्रा में मौजूद होते हैं जो सेहत पर प्रभावी होते हैं। आप साबुत लौंग और इसके निकाले गए तेल का इस्तेमाल भी कर सकते हैं। आज इस कड़ी में हम आपको बताने जा रहे हैं कि लौंग के सेवन से किन समस्याओं का निवारण किया जा सकता हैं। आइये जानते हैं...

इम्यूनिटी को मजबूत बनाने में फायदेमंद
इम्यूनिटी को मजबूत बनाने के लिए लौंग का सेवन करना बहुत ही फायदेमंद माना जाता है। क्योंकि लौंग में विटामिन सी और एंटी ऑक्सीडेंट के गुण पाए जाते हैं, जो इम्यूनिटी को मजबूत बनाने में मदद करते हैं।

स्पर्म काउंट बढ़ाए
लौंग पुरुष स्वास्थ्य के लिए काफी फायदेमंद होता है। लौंग का सेवन करने से स्पर्म काउंट बढ़ाने में मदद मिलती है। लेकिन आपको इसका सेवन सीमित मात्रा में या डॉक्टर की सलाह पर ही करना चाहिए। अधिक मात्रा में लौंग खाने से टेस्टोस्टेरॉन हार्मोन गड़बड़ा जाता है। टेस्टोस्टेरॉन एक मेल हार्मोन है। पुरुष अपनी स्टैमिना बढ़ाने के लिए भी लौंग का सेवन कर सकते हैं।

दांतों के लिए फायदेमंद
लौंग में एंटी माइक्रोबियल गुण होते हैं। ये बुरे बैक्टीरिया के विकास को रोकने में मदद करते हैं। इसी वजह से ये ओरल हेल्थ में मददगार साबित होते हैं। इससे दांत दर्द में भी आराम मिलता है। आप मुंह में दर्द वाली जगह पर कुछ मिनट के लिए एक लौंग रख सकते हैं। ये दर्द से राहत दिलाने का काम करता है। अगर हर्बल टूथपेस्ट में इस्तेमाल किया जाए तो ये प्लेग और दांतों की सड़न को खत्म करने में मदद कर सकता है।

पेट से जुड़ी समस्या को दूर करने में फायदेमंद
पेट से जुड़ी समस्या को दूर करने के लिए लौंग का सेवन करना बहुत ही फायदेमंद माना जाता है। क्योंकि लौंग में फाइबर की भरपूर मात्रा होती है जो पाचन को बेहतर बनाने में मदद करता है। साथ ही ये पेट से जुड़ी समस्या को दूर करता है।
बैक्टीरिया से बचाने में सहायक
लौंग में रोगाणुरोधी गुण पाए गए हैं, जिसका अर्थ है कि ये बैक्टीरिया जैसे सूक्ष्मजीवों के विकास को रोकने में मदद कर सकता है। टेस्ट-ट्यूब अध्ययन से पता चलता है कि लौंग के तेल में ई. कोलाई सहित कई अन्य बैक्टीरिया को मारने का गुण होता है। यह फूड पॉइजनिंग का कारण बनने वाले बैक्टीरिया से भी आपको सुरक्षित रखने में सहायक हो सकता है। इसके अलावा लौंग के जीवाणुरोधी गुण मौखिक स्वास्थ्य को बढ़ावा देने में भी मदद कर सकते हैं, जिससे दांतों-मसूड़े की बीमारी का जोखिम कम हो जाता है।

यौन संबंधी समस्याएं दूर करे
आयुर्वेदाचार्य यौन संबंधी समस्याओं से परेशान पुरुषों को लौंग खाने की सलाह देते हैं। रोजाना तय मात्रा में लौंग खाने से पौरुष संबंधी दिक्कतें दूर होती हैं। अगर आपको भी यौन संबंधी समस्याओं का सामना करना पड़ता है, तो रोज सुबह खाली पेट 3-4 लौंग गुनगुने पानी के साथ ले सकते हैं। लौंग में मौजूद तत्व पुरुषों के स्टैमिना को बढ़ाने में मदद करते हैं।

सिर दर्द से राहत दिलाने में फायदेमंद
सिर दर्द से राहत पाने के लौंग का इस्तेमाल करना बहुत ही फायदेमंद माना जाता है। क्योंकि लौंग यूजेनॉल मौजूद होता है जो सिर दर्द से राहत दिलाने में मदद करता है। इसलिए सिर दर्द से राहत पाने के सिर पर लौंग का तेल लगाएं।

लिवर की सेहत के लिए फायदेमंद
अध्ययनों से पता चलता है कि लौंग में पाए जाने वाले फायदेमंद यौगिक, लिवर के स्वास्थ्य को बढ़ावा देने में मदद कर सकते हैं। लौंग में पाया जाने वाला यूजेनॉल यौगिक लिवर की सेहत के लिए विशेष रूप से फायदेमंद हो सकता है। फैटी लिवर के शिकार चूहों को लौंग देकर उनमें लिवर के सूजन को कम करने में मदद मिली। एक अन्य पशु अध्ययन से पता चलता है कि लौंग में पाए जाने वाला यूजेनॉल यौगिक लिवर सिरोसिस या लिवर स्केरिंग के खतरे को भी कम करने में मदद कर सकता है।

मुंह की दुर्गंध को दूर करने में फायदेमंद
मुंह की दुर्गंध को दूर करने
के लिए लौंग का सेवन करना बहुत ही फायदेमंद माना जाता है। क्योंकि लौंग एक
बेहतरीन माउथफ्रेशनर है जो मुंह की दुर्गंध को दूर करने में मदद करता है।
इसलिए मुंह की दुर्गंध को दूर करने लौंग का सेवन जरूर करें।














